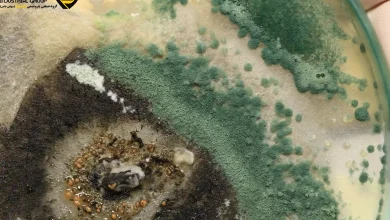
قبل از خرید ضد کپک صنعتی، این 3 نکته حیاتی رو بدون!

مواد اولیه شیمیایی
شرکت پتروشیمی دانشمند تولید کننده و ارائه دهنده مواد اولیه شیمیایی با قیمت مناسب و کیفیت بالا است
- 
	
			
پلی آکریل آمید برای پوست | 3 حقیقت که باید بدانید!
مقدمه آیا تا به حال به ترکیبات روی بستهبندی کرم یا سرم پوست دقت کردهاید؟ نامهای علمی و گاهی عجیب…
بیشتر بخوانید » - 
	
			
قبل از خرید ضد کپک صنعتی، این 3 نکته حیاتی رو بدون!
در بسیاری از صنایع شیمیایی و تولیدی، رشد کپک و قارچ میتواند کیفیت نهایی محصول را کاهش دهد. این مشکل…
بیشتر بخوانید » - 
	
			
نشادر جوشکاری | 5 نقش اساسی آن در فلزکاری صنعتی
نشادر جوشکاری یا کلرید آمونیوم (Ammonium Chloride) از مواد حیاتی در فرآیندهای لحیمکاری، گالوانیزه و جوشکاری نرم است که نقش…
بیشتر بخوانید » - 
	
			
آیا کلر در سال 2025، انتخابی مطمئن برای صنایع است؟
کلر؛ از تاریخچه تا نقش کلیدی در زندگی امروز ما کلر (Chlorine)، که در برخی صنایع با نام هیپوکلریت کلسیم…
بیشتر بخوانید » - 
	
			
راهنمای جامع خرید پلی اتیلن واکس 30% با بهترین قیمت
پلی اتیلن واکس 30%؛ انتخابی هوشمندانه برای تولید باکیفیت و اقتصادی پلی اتیلن واکس 30% یکی از پرکاربردترین امولسیونهای صنعتی…
بیشتر بخوانید » - 
	
			
هیدروسولفیت سدیم چینی | 3 روش شناسایی اصل از تقلبی
هیدروسولفیت سدیم چینی: راهنمای کامل خرید و شناسایی اصل از تقلبی اگر در صنایع نساجی، کاغذ، چرم، یا حتی صنایع…
بیشتر بخوانید » - 
	
			
MSDS پلی الکترولیت،ضد کف،PAC،بایوساید؛ 5 نکته ایمنی
MSDS مواد شیمیایی آب و فاضلاب: پلیالکترولیت، ضد کف، پلی آلومینیوم کلراید و بایوساید ایزوتیازولین برگه اطلاعات ایمنی مواد (MSDS)…
بیشتر بخوانید » - 
	
			
تینر فوری در صنعت رنگ | 4 کاربرد، مزایا و نکات کلیدی
تینر فوری در صنعت رنگ | کاربردها، مزایا و نکات کلیدی مقدمه در صنعت رنگ و پوششهای صنعتی، انتخاب…
بیشتر بخوانید » - 
	
			
خرید سدیم هیدروکسید (سود پرک) 25 کیلویی، سود مایع حواله
سدیم هیدروکسید NaOH یا سود پرک : هیدروکسید سدیم که به طور تجاری به عنوان سود سوزآور، کاستیک و سود…
بیشتر بخوانید »